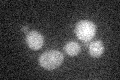
YLR260W
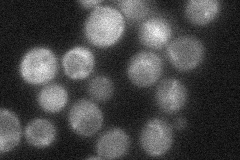
YLR260W
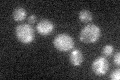
YLR260W

View description
Minor sphingoid long-chain base kinase, paralog of Lcb4p responsible for few percent of the total activity, possibly involved in synthesis of long-chain base phosphates, which function as signaling molecules
Localization:
Intensity:
Fold change:
Significance:
-
C’ GFP library in SD
below threshold15.79 -
N' NOP1pr-GFP in SD

cytosol71.3415 -
N' TEF2pr-mCherry in SD

cytosol112.759 -
N' NATIVEpr-GFP in SD
cytosol29.5376 -
N' TEF2pr-VC and Cyto-VN in SD

below threshold27.0399 -
C’ GFP library in SD+DTT

cytosol17.841.12No -
C’ GFP library in SD+H2O2
cytosol17.571.11No -
C’ GFP library in Starvation Media

cytosol12.610.79No -
C’ GFP library on the background of Pup2-DaMP

below threshold -
C’ GFP library on the background of CCT mutant

below threshold17.57161.11192No
